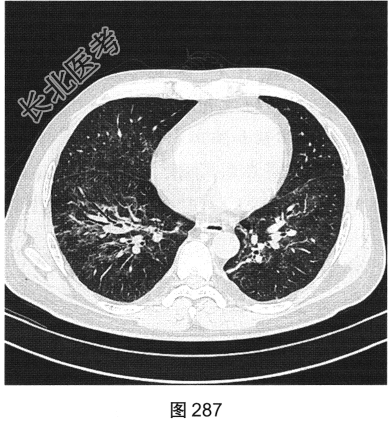

试题详情
- [材料题] 患者男性,33岁,因“双下肢散在皮下出血点伴尿检异常3个月余,咳嗽、胸闷伴发热一周”就诊。患者脂肪肝、胆囊炎,服用莲葡双清片;随后几日内食用淡水鱼、鱿鱼、饮啤酒;5天后出现双下肢散在皮下出血点,未重视;10天后出现腹痛,在当地医院检查尿中有蛋白、定量不详,血常规检查正常,肾功能正常,应用醋酸泼尼松效果欠佳,行肾活检术,病理诊断:紫癜性肾炎,继发IgA肾病。患者每天静脉滴注甲泼尼龙0.5g,共3天,后改为口服甲泼尼龙28mg/d,共35天。一周前着凉后出现咳嗽、胸闷伴发热,体温达39.1℃,于当地医院抗炎治疗效果欠佳,遂来本院。实验室检查:血白细胞计数6.92×109/L,中性粒细胞0.845,CRP为2.7mg/dl。患者PP65阳性。胸部CT检查如图284~图287所示。

- 多项选择题1.患者的主要影像特征是( )
A、双下肺为著
B、伴细网格影
C、血管支气管束增厚
D、小叶中央结节
E、以磨玻璃密度为主
F、双肺弥漫分布
关注下方微信公众号,搜题查看答案

- 多项选择题2.根据患者病史和影像特征,您的诊断是( )
A、肺结核
B、巨细胞病毒感染
C、急性肺泡损害
D、外源性过敏性肺泡炎
E、肺水肿
F、肺孢子菌感染
关注下方微信公众号,搜题查看答案

- 多项选择题3.常用的临床检测方法包括( )
A、活检
B、痰检病原菌
C、抗体检测
D、mRNA蛋白检测
E、体液检测
F、抗原检测
关注下方微信公众号,搜题查看答案

- 多项选择题4.该病的常见影像表现有( )
A、空洞
B、双肺磨玻璃影
C、淋巴结增大
D、实变
E、小叶中央结节一树芽征
F、血管支气管束和小叶间隔增厚
关注下方微信公众号,搜题查看答案

热门试题
- 男,21岁, 高热1周伴胸痛,胸片如图,
- 创伤性心包出血 ( )A、X线胸
- 关于肺动脉栓塞的CT表现,下列哪项最具有
- 有关矽肺的叙述正确的是A、早期可出现间隔
- 肺结核大于5mm的小结节多为( )。
- 吸入性肺脓肿的好发部位是下列哪项 (
- 肺转移瘤并发自发性气胸,以下列哪种原发肿
- 关于正常胸腺的CT表现,描述错误的是A、
- 男,68岁, 咳嗽,气喘10年, 桶状胸
- 患者,女, 46岁。主因胸闷气短1个月来
- 肺部疾病最重要基本的检查方法是A、CTB
- 女,18岁, 1年前患肺结核经抗结核治疗
- 肺癌细短毛刺形成的病理基础是 (
- 大叶性肺炎的CT征象不包括A、肺中实质呈
- 周围型肺癌的CT图像可见下列哪些特征(
- 下述哪些属硅酸盐肺 ( )A、
- 关于肺韦格肉芽肿的描述,不正确的是
- 肺内病灶与钙化对应的关系,下列正确的是A
- 肺错构瘤的典型钙化是( )A、沙砾样
- 肺癌支气管动脉化疗的适应证为A、晚期不能